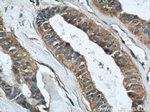
RINT1 Antibody in Immunohistochemistry (Paraffin) (IHC (P))

Search
Proteintech
RINT1 Polyclonal Antibody
{{$productOrderCtrl.translations['antibody.pdp.commerceCard.promotion.promotions']}}
{{$productOrderCtrl.translations['antibody.pdp.commerceCard.promotion.viewpromo']}}
{{$productOrderCtrl.translations['antibody.pdp.commerceCard.promotion.promocode']}}: {{promo.promoCode}} {{promo.promoTitle}} {{promo.promoDescription}}. {{$productOrderCtrl.translations['antibody.pdp.commerceCard.promotion.learnmore']}}
产品信息
14567-1-AP
种属反应
宿主/亚型
分类
类型
抗原
偶联物
形式
浓度
规格
纯化类型
保存液
内含物
保存条件
运输条件
产品详细信息
Immunogen sequence: RWLTVERKF ALQKMDSMLS SEAAWVSQYK DITDVDEMKV PDCAETFMTL LLVITDRYKN LPTASRKLQF LELQKDLVDD FRIRLTQVMK EETRASLGFR YCAILNAVNY ISTVLADWAD NVFFLQLQQA ALEVFAENNT LSKLQLGQLA SMESSVFDDM INLLERLKHD MLTRQVDHVF REVKDAAKLY KKERWLSLPS QSEQAVMSLS SSACPLLLTL RDHLLQLEQQ LCFSLFKIFW QMLVEKLDVY IYQEIILANH FNEGGAAQLQ FDMTRNLFPL FSHYCKRPEN YFKHIKEACI VLNLNVGSAL LLKDVLQSAS GQLPATAALN EVGIYKLAQQ DVEILLNLRT NWPNTGK (437-792 aa encoded by BC068483 )
靶标信息
Involved in regulation of membrane traffic between the Golgi and the endoplasmic reticulum (ER); the function is proposed to depend on its association in the NRZ complex which is believed to play a role in SNARE assembly at the ER. May play a role in cell cycle checkpoint control. Essential for telomere length control.
仅用于科研。不用于诊断过程。未经明确授权不得转售。
篇参考文献 (0)
生物信息学
蛋白别名: HsRINT-1; RAD50 interactor 1; RAD50-interacting protein 1; RINT-1; unnamed protein product
基因别名: 1500019C06Rik; 2810450M21Rik; ILFS3; RGD1560433; RINT-1; RINT1
UniProt ID: (Human) Q6NUQ1, (Mouse) Q8BZ36
Entrez Gene ID: (Human) 60561, (Mouse) 72772, (Rat) 296750